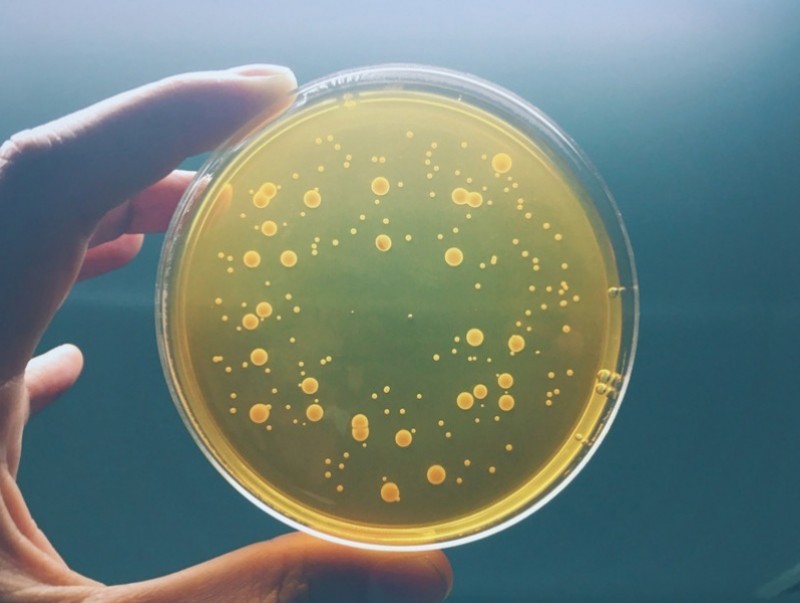

Бичил биетний тэсвэржилтээс хамтдаа сэргийлье! “Бичил биетний тэсвэржилтийн талаарх мэдлэг, хандлагыг сайжруулах дэлхийн 7 хоног” эхэлж байна.
Энэхүү аянг жил бүрийн 11-р сарын 18-24-ний хооронд Дэлхийн эрүүл мэндийн байгууллага, НҮБ-ын Хүнс, хөдөө аж ахуйн байгууллага, Дэлхийн мал, амьтны эрүүл мэндийн байгууллага, НҮБ-ын Байгаль орчны хөтөлбөр гэсэн олон улсын 4 байгууллага уламжлал болгон Дэлхий даяар тэмдэглэн өнгөрүүлдэг.

Бичил биетэн гэдэгт нян, вирус, мөөгөнцөр, шимэгчийг хамааруулах бөгөөд бичил биетнийг устгадаг эсвэл түүний үржил, хөгжлийг нь саатуулах үйлчилгээ үзүүлдэг аливаа эм, бэлдмэлийг бичил биетний эсрэг эм (ББЭЭ) гэнэ.
Харин бичил биетний тэсвэржилт (ББТ) гэдэг нь өвчин үүсгэгч нян, вирус, шимэгч хорхой, мөөгөнцөр зэрэг бичил биетэн ББЭЭ-нд дасал болж эмчилгээ, үйлчилгээ үр дүнгүй болохыг хэлнэ.
Бичил биетний тэсвэржилт үүсэх үндсэн шалтгаан нь бичил биетний эсрэг эмийг хэтрүүлэн хэрэглэх, эсвэл дутуу, буруу давтамжтай зохисгүй хэрэглэх явдал юм. Мөн малчид, тариаланчид бичил биетний эсрэг эмийг мал аж ахуй, газар тариаланд хяналтгүй хэрэглэснээр бичил биетний тэсвэржилтийн тархалтыг нэмэгдүүлэх нөхцөл бүрдэж байна.
Монгол улсад Хүнс, хөдөө аж ахуй, хөнгөн үйлдвэрийн сайд, Эрүүл мэндийн сайдын хамтарсан тушаалаар “Бичил биетний тэсвэржилтээс сэргийлэх салбан дундын үйл ажиллагааны төлөвлөгөө” 2022-2025 батлагдан харьяа байгууллагууд хэрэгжүүлэн ажиллаж байна гэж Мал эмнэлгийн ерөнхий газраас мэдээллээ.




| “Бичил биетний тэсвэржилтийн талаарх мэдлэг, хандлагыг сайжруулах дэлхийн 7 хоног” эхэллээ | ||
| Үзсэн: 1379 | Mongolian National Broadcaster |


 Үндэсний телевиз
Үндэсний телевиз



























































































































 Р.Слава
Р.Слава

 Б.Цоожчулуунцэцэг
Б.Цоожчулуунцэцэг

 М.Тодхүү
М.Тодхүү





Сэтгэгдэл бичих:
АНХААРУУЛГА: Уншигчдын бичсэн сэтгэгдэлд MNB.mn хариуцлага хүлээхгүй болно. ТА сэтгэгдэл бичихдээ хууль зүйн болон ёс суртахууны хэм хэмжээг хүндэтгэнэ үү. Хэм хэмжээг зөрчсөн сэтгэгдэлийг админ устгах эрхтэй. Сэтгэгдэлтэй холбоотой санал гомдолыг 70127055 утсаар хүлээн авна.